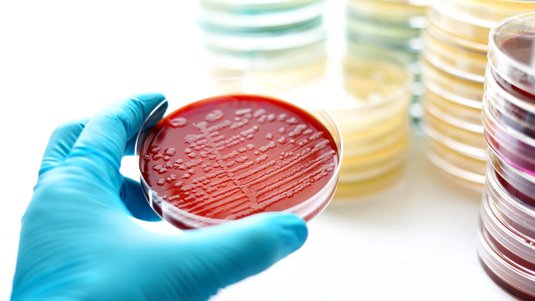
Mikrobiologie – Einführung in die Welt der Mikroorganismen, Teil 1/3

Jodhaltige Lösungen in der Wundversorgung – sinnvoll oder veraltet?
Jod (oder: Iod) wird seit mehr als 150 Jahren als Antiseptikum in der Wundversorgung eingesetzt. Aktuelle Empfehlungen schränken die Indikationen für jodhaltige Lösungen (Iodophore) zur Wunddesinfektion deutlich ein. Welchen Stellenwert hat Jod heute noch?
Welche Eigenschaften hat Jod in der Wundversorgung?
Jod (oder wissenschaftlich: Iod) gehört chemisch zur Gruppe der Halogene wie zum Beispiel Chlor. Biologisch wirksam ist das molekulare Iod (I2) wie es unter anderem in Povidon-Jod (PVP-Jod; oder Povidon-Iod) enthalten ist.1-3
Mit Blick auf die Wundantiseptik zeigt Jod eine Reihe günstiger Eigenschaften:
1. Jod besitzt eine breite mikrobielle Wirkung gegen:1-3,5
- Bakterien
- Bakteriensporen (bei längerer Einwirkzeit von 2 bis 24 Stunden)
- Hefen, Schimmelpilze und Dermatophyten
- Behüllte und unbehüllte Viren
- Protozoen
2. Jod entfaltet seine antimikrobielle Wirkung bereits innerhalb von 5 bis 30 Minuten. Bei der Verwendung von jodhaltigen Produkten sollten immer die zeitlichen Angaben des Herstellers beachtet werden.2,3
3. Für Jod sind bislang keine nennenswerten Resistenzen bekannt.1-3
4. Jod kann Biofilme durchdringen (auch periodontale Biofilme)1-3
5. Man vermutet für Jod eine entzündungshemmende Wirkung, da es in vitro die Bildung und Freisetzung von Entzündungsbotenstoffen hemmt.2,3,5
Allerdings kann Jod teilweise hemmend auf die Wundheilung wirken.2-4
Der genaue antimikrobielle Wirkmechanismus von Jod wurde bislang noch nicht genau erforscht. Man vermutet, dass Jod lebenswichtige, bakterielle Zellmechanismen und -strukturen hemmt beziehungsweise denaturiert.5 Dies kann zu einem "Eiweißfehler" führen, da durch die Eiweiße (Blut, Eiter und Exsudat) Jod inaktiviert wird.4
Beim Einsatz von Jod ist seine färbende Eigenschaft zu beachten, da sie die Beurteilung des Wundgrundes erschweren kann.
Wichtig zu wissen: Im Gegensatz zu anderen Antiseptika besitzt Jod in Povidon-Jod keine echte, remanente (länger andauernde) Wirkung. Vielmehr hängt die verlängerte Wirkdauer mit der verzögerten Freisetzung von Jod aus dem PVP-Molekül zusammen.2,3
Wundantiseptik und Mikroorganismen: Fortbildung mit DRACO Wunde+
Was ist Povidon-Jod (PVP-Jod)?
Povidon-Jod gehört zu den sogenannten „Iodophoren“. Dabei wird das molekulare Jod (I2) in einem „Trägersystem“ aus Makromolekülen/Polymeren als Komplex gebunden, der wasserlöslich ist. Das Trägersystem hat selbst keine antimikrobiellen Eigenschaften.2,3,5
Bei Povidon-Jod besteht das Trägersystem aus Polyvinylpyrrolidon (PVP). Nach der Applikation auf die Haut gibt das PVP die Jod-Moleküle kontinuierlich ab. Povidon-Jod hat im Vergleich zu wässrigen oder alkoholischen Jod-Lösungen die folgenden Vorteile:2,3,5
- Geringere Jodresorption im Körper
- Geringere Zytotoxizität
- Geringere Sensibilisierung
- Insgesamt bessere Verträglichkeit
Außerdem enthält das Povidon-Jod mehr mikrobiell aktives Jod als wässrige Jod-Lösungen, in denen etwa nur ein Tausendstel des Gesamtiods frei vorliegt.2,3
Povidon-Jod steht unter anderem als 10%-ige, wässrige Lösung und als Salbe („Jodsalbe“) zur Verfügung.1
Was sind die Einsatzgebiete von Jod in der Wundversorgung?
Generell sind Wundantiseptika wie jodhaltige Lösungen zur Prävention oder Behandlung von Wundinfektionen indiziert.2,3
Der aktuelle Expertenkonsensus zu Wundantiseptika empfiehlt PVP-Jod als Mittel der Wahl bei:2,3
Dagegen sind wässrige Povidon-Jod-Lösungen in der typischen Konzentration von 10% aufgrund ihrer Zytotoxizität nicht für die wiederholte Anwendung bei chronischen Wunden und auf Spalthauttransplantanten geeignet. Hier und auch bei Verbrennungswunden gilt Polihexanid als Mittel der Wahl.2-4
Der Expertenkonsensus zu Wundantiseptika nennt noch eine weitere Einsatzmöglichkeit für Jod: Dank seiner antiseptischen und zytotoxischen Eigenschaften bietet es sich an, Jod in Form von Jod-Gaze zur Behandlung von Hypergranulationen anzuwenden. Dabei wirkt Jod gegen sogenannte „low-grade“-Infektionen.2,3
Kontraindikationen für die Anwendung jodhaltiger Lösungen
Jodhaltige Lösungen können jedoch zu einer Reihe von Nebenwirkungen führen. So besteht bei ihrer Anwendung ein erhöhtes Risiko für Schilddrüsenfunktionsstörungen (bis hin zur lebensbedrohlichen jodinduzierten, thyreotoxischen Krise) und für eine Sensibilisierung (allergisches Potenzial).2-4
Darüber hinaus sind jodhaltige Lösungen kontraindiziert:2,3
- Bei Allergien
- Bei hyperthyreoten Schilddrüsenerkrankungen (Schilddrüsenüberfunktion)
- Bei Dermatitis herpetiformis Duhring
- Vor und nach einer Radioiodtherapie
- Zur Peritoneallavage
Bei dem in den USA und Großbritannien gebräuchlicheren Iodophor Cadexomer-Iod (C-I) bestehen zusätzliche Kontraindikationen:2,3
- Hashimoto-Thyreoiditis
- Schwangerschaft und Stillzeit
- Bei Kindern unter 12 Jahren
Was gilt für jodhaltige Wundauflagen?
Neben jodhaltigen Lösungen und Salben stehen auch antimikrobielle Wundauflagen mit Jod zur Verfügung. Dazu werden Cadexomer-Iod oder Povidon-Iod in Okklusivverbände wie Hydrokolloide und Hydrogele eingearbeitet. Sie können zum Beispiel bei Wunden mit einem hohen Infektionsrisiko angewendet werden.6
Allerdings besteht bei jodhaltigen Wundauflagen das Risiko einer systemischen Jodadsorption, was in der Folge zu Schilddrüsenfunktionsstörungen führen kann. Deshalb wird bei ihrer Anwendung eine Kontrolle der Schilddrüsenfunktion empfohlen. Bei Kindern, schwangeren und stillenden Frauen sowie bei Menschen mit einer Schilddrüsenfunktionsstörung oder Jodsensitivität in der Vorgeschichte sollten jodhaltige Verbandmittel nicht verwendet werden.6
Evidenz-Check für jodhaltige Lösungen in der Wundversorgung
Neben den bereits genannten Empfehlungen für jodhaltige Lösungen zur Versorgung akuter Wunden, gibt es „klassische“ Anwendungsgebiete wie zum Beispiel Bagatellverletzungen bei Kindern oder die Hautdesinfektion vor Operationen. In beiden Fällen werden sie nicht (mehr) empfohlen:7,8
- Aseptik des OP-Feldes: Die Kommission für Krankenhaushygiene und Infektionsprävention (KRINKO) beim Robert Koch-Institut empfiehlt Alkohol-basierte Präparate mit Zugabe eines remanent wirkenden Antiseptikums (wie Chlorhexidin oder Octenidindihydrochlorid). Die Anwendung von Povidon-Jod wird nicht explizit empfohlen.7
- Wundversorgung bei Kindern: Die aktuelle S1-Leitlinie „Wunden und Wundbehandlung im Kindesalter“ empfiehlt weder in der primären noch sekundären Wundversorgung (zum Beispiel infizierte Wunden) jodhaltige Lösungen. Zur Wund- und Umgebungsreinigung sollen demnach physiologische Lösungen (NaCl 0,9 %, Ringer) oder Wasser und Seife mit nicht brennenden Antiseptika wie Polihexanid und Octenidin verwendet werden.8